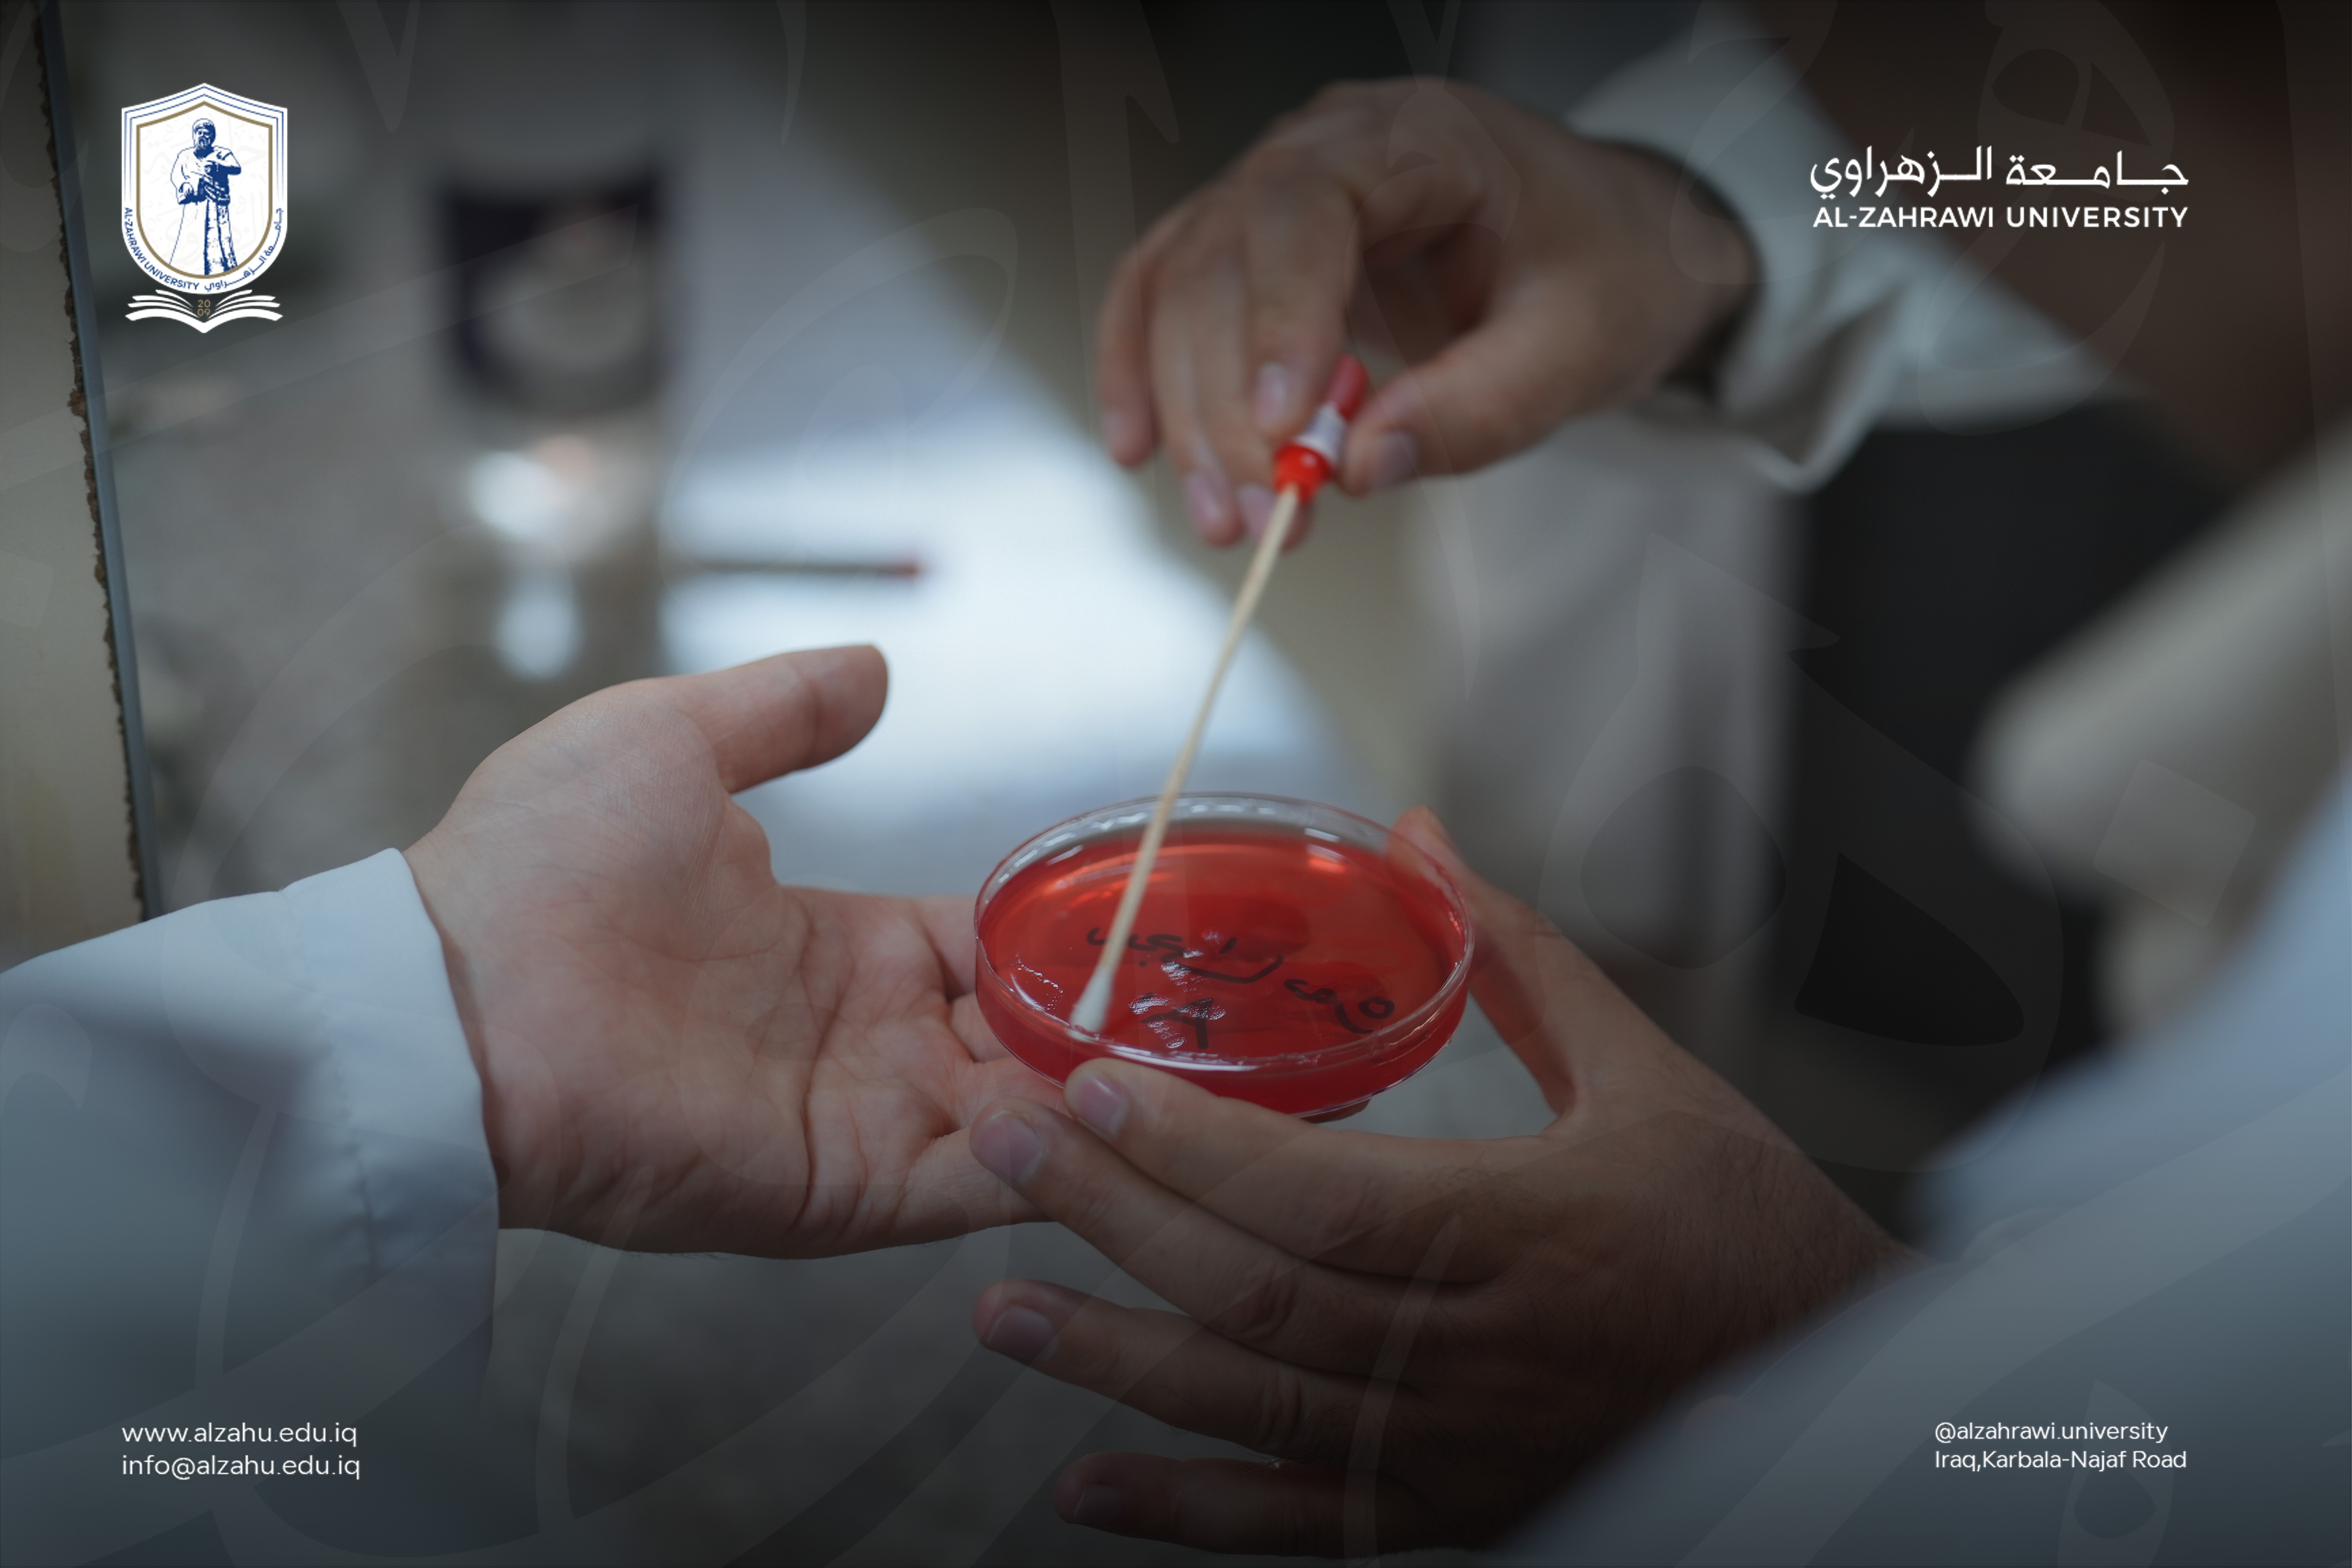

الاخبار
 الاخبار
الاخبار
06-19 AM
|
2026-04-22
220
مشاهدة
شعبة شوون المراة في جامعة الزهراوي تقيم بازار
شعبة شوون المراة في جامعة الزهراوي تقيم بازار اقامت شعبة شوون المراة في جامعة الزهراوي /وبالتعاون مع كلية الصيدلة (بزار لدعم المشاريع الصغيرة للطالبات ) في يوم الاربعاءالمصادف 15/4/2026
 اكثر مشاهدة
اكثر مشاهدة